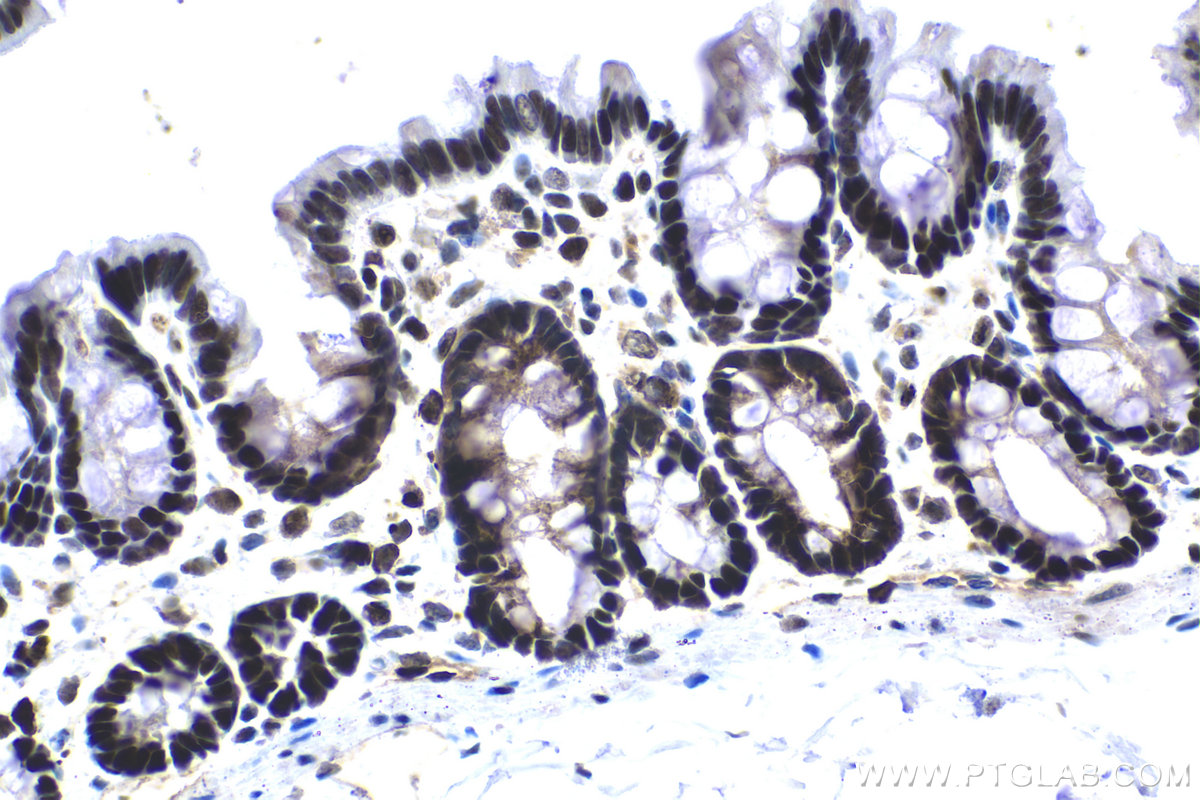

IHCeasy® APEX1 Ready-To-Use IHC Kit
APEX1 Ready-to-use reagent kit for IHC.
Reactivity
Human, Mouse, Rat
Sample Type
FFPE tissue
Cat no : KHC1569
Synonyms
AP endonuclease 1, APE, APE1, APE1,APEX1, APEN, APEX, APEX nuclease, APEX1, APX, HAP1, Protein REF 1, REF1
Validation Data Gallery
Product Information
KHC1569 is a ready-to-use IHC kit for staining of APEX1. The kit provides all reagents, from antigen retrieval to cover slip mounting, that require little to no diluting or handling prior to use. Simply apply the reagents to your sample slide according to the protocol and you're steps away from obtaining high-quality IHC data.
| Product name | IHCeasy APEX1 Ready-To-Use IHC Kit |
| Sample type | FFPE tissue |
| Assay type | Immunohistochemistry |
| Primary antibody type | Mouse Monoclonal |
| Secondary antibody type | Polymer-HRP-Goat anti-Mouse |
| Reactivity | Human, Mouse, Rat |
Kit components
| Component | Size | Concentration |
|---|---|---|
| Antigen Retrieval Buffer | 100 mL | 50× |
| Washing Buffer | 100 mL ×2 | 20× |
| Blocking Buffer | 5 mL | RTU |
| Primary Antibody | 5 mL | RTU |
| Secondary Antibody | 5 mL | RTU |
| Chromogen Component A | 0.2 mL | RTU |
| Chromogen Component B | 4 mL | RTU |
| Signal Enhancer | 5 mL | RTU |
| Counter Staining Reagent | 5 mL | RTU |
| Mounting Media | 5 mL | RTU |
| Datasheet | 1 Copy | |
| Manual | 1 Copy |
Background Information
APEX1, also named as APE, APE1, HAP1 and REF-1, belongs to the DNA repair enzymes AP/ExoA family. It is a multifunctional protein that plays a central role in the cellular response to oxidative stress. The two major activities of APEX1 are in DNA repair and redox regulation of transcriptional factors. APEX nuclease is a DNA repair enzyme having apurinic/apyrimidinic (AP) endonuclease, 3-prime,5-prime-exonuclease, DNA 3-prime repair diesterase, and DNA 3-prime-phosphatase activities. On the other hand, APEX1 also exerts reversible nuclear redox activity to regulate DNA binding affinity and transcriptional activity of transcriptional factors by controlling the redox status of their DNA-binding domain, such as the FOS/JUN AP-1 complex after exposure to IR. APEX1 is involved in calcium-dependent down-regulation of parathyroid hormone (PTH) expression by binding to negative calcium response elements (nCaREs). When acetylated at Lys-6 and Lys-7, APEX1 stimulates the YBX1-mediated MDR1 promoter activity, leading to drug resistance. It also acts as an endoribonuclease involved in the control of single-stranded RNA metabolism. It plays a role in regulating MYC mRNA turnover by preferentially cleaving in between UA and CA dinucleotides of the MYC coding region determinant (CRD). In association with NMD1, APEX1 plays a role in the rRNA quality control process during cell cycle progression.
Properties
| Storage Instructions | All the reagents are stored at 2-8°C. The kit is stable for 6 months from the date of receipt. |
| Synonyms | AP endonuclease 1, APE, APE1, APE1,APEX1, APEN, APEX, APEX nuclease, APEX1, APX, HAP1, Protein REF 1, REF1 |